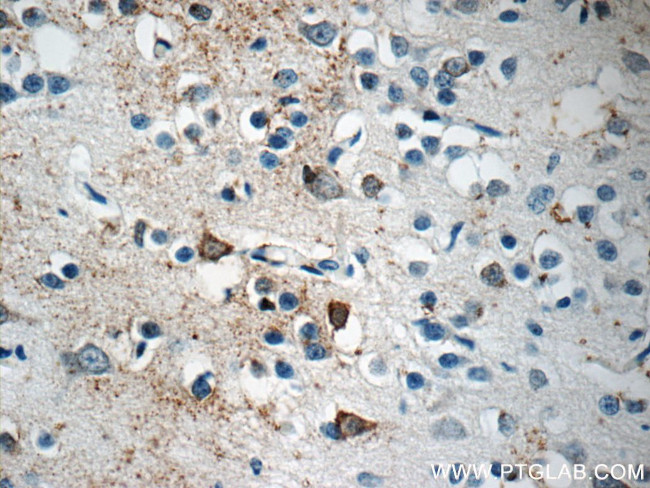
LRRTM1 Antibody in Immunohistochemistry (Paraffin) (IHC (P))

Search
Proteintech
LRRTM1 Polyclonal Antibody
{{$productOrderCtrl.translations['antibody.pdp.commerceCard.promotion.promotions']}}
{{$productOrderCtrl.translations['antibody.pdp.commerceCard.promotion.viewpromo']}}
{{$productOrderCtrl.translations['antibody.pdp.commerceCard.promotion.promocode']}}: {{promo.promoCode}} {{promo.promoTitle}} {{promo.promoDescription}}. {{$productOrderCtrl.translations['antibody.pdp.commerceCard.promotion.learnmore']}}
产品信息
14288-1-AP
种属反应
宿主/亚型
分类
类型
抗原
偶联物
形式
浓度
规格
纯化类型
保存液
内含物
保存条件
运输条件
产品详细信息
Immunogen sequence: QMLPAAPSG CPQLCRCEGR LLYCEALNLT EAPHNLSGLL GLSLRYNSLS ELRAGQFTGL MQLTWLYLDH NHICSVQGDA FQKLRRVKEL TLSSNQITQL PNTTFRPMPN LRSVDLSYNK LQALAPDLFH GLRKLTTLHM RANAIQFVPV RIFQDCRSLK FLDIGYNQLK SLARNSFAGL FKLTELHLEH NDLVKVNFAH FPRLISLHSL CLRRNKVAIV VSSLDWVWNL EKMDLSGNEI EYMEPHVFET VPHLQSLQLD SNRLTYIEPR ILNSWKSLTS ITLAGNLWDC GRNVCALASW LSNFQGRYDG NLQCASPEYA QGE (30-351 aa encoded by BC045113)
靶标信息
The Leucine-rich repeat transmembrane neuronal proteins (LRRTMs) are differentially expressed in the nervous system and were recently found to instruct presynaptic and mediate postsynaptic glutamatergic differentiation, with LRRTM1 and LRRTM2 most potent at inducing presynaptic differentiation. Each LRRTM protein is a type I transmembrane containing ten extracellular leucine-rich repeats and a short intracellular tail and has a developmentally regulated pattern distinct from all others. LRRTM1 is a maternally suppressed gene that is associated paternally with handedness and schizophrenia.
仅用于科研。不用于诊断过程。未经明确授权不得转售。
篇参考文献 (0)
生物信息学
蛋白别名: leucine-rich repeat transmembrane neuronal 1; leucine-rich repeat transmembrane neuronal 1 protein; Leucine-rich repeat transmembrane neuronal protein 1; unnamed protein product
基因别名: 4632401D06Rik; AW125451; LRRTM1; UNQ675/PRO1309
UniProt ID: (Rat) D4A6D8, (Human) Q86UE6, (Mouse) Q3UVX1
Entrez Gene ID: (Rat) 679668, (Human) 347730, (Mouse) 74342